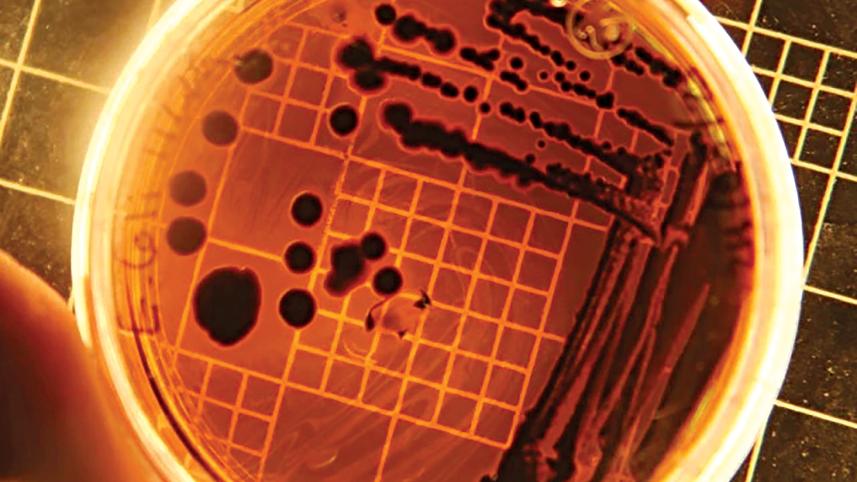
ecoli.jpg

E.coli bacteria can turn plastic into painkillers
Scientists have found a way to use the bacteria E.Coli to convert plastic waste into a popular painkiller, a study said Monday, though outside experts doubted the technique would make a dent in the fight against plastic pollution.
Paracetamol, which is one of the most commonly used drugs worldwide, is made from the derivatives of fossil fuels, often by Asia-based subcontractors using cheap, polluting methods that contribute to climate change.
The British team of researchers behind the new study sought to find a solution to the two problems by roping in a third -- E.coli, which is normally known for making people sick when they eat contaminated food.
First the chemists used a molecule derived from PET plastic to spark a chemical reaction in a strain of E.coli.
This created a molecule they called PABA, according to the Nature Chemistry study, which was partly funded by drug firm AstraZeneca.
By genetically modifying the bacteria, the chemists were able to transform their molecule into acetaminophen, also known as paracetamol.
"This work demonstrates that PET plastic isn't just waste or a material destined to become more plastic -- it can be transformed by microorganisms into valuable new products, including those with potential for treating disease," lead study Stephen Wallace said in a statement.



 For all latest news, follow The Daily Star's Google News channel.
For all latest news, follow The Daily Star's Google News channel.
Comments